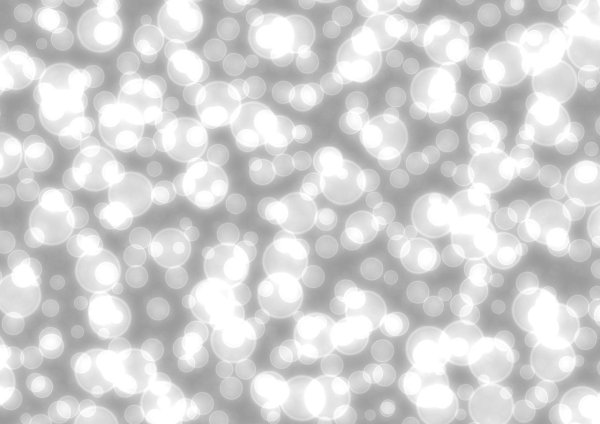
Эффект боке

Ищете идеальную картинку с эффектом белого боке на прозрачном фоне? Тогда вы попали по адресу! Наша коллекция изображений предлагает разнообразные варианты, где белое боке создает красивый эффект размытия фона. Этот стильный и эстетичный эффект добавит нежность и романтику вашим проектам, будь то дизайн веб-сайта, рекламный постер или любой другой творческий проект. Выбирайте из нашей коллекции идеальную картинку, чтобы придать вашему проекту особый шарм и привлекательность.
![Огоньки боке на черном фоне]()
Огоньки боке на черном фоне
![Белые блики на прозрачном фоне]()
Белые блики на прозрачном фоне
![Серые блики]()
Серые блики
![Серые блики]()
Серые блики
![Блики на прозрачном фоне]()
Блики на прозрачном фоне
![Розовые кружочки]()
Розовые кружочки
![Блики для фотошопа на прозрачном фоне]()
Блики для фотошопа на прозрачном фоне
![Боке для фотошопа]()
Боке для фотошопа
![Бежевый фон с бликами]()
Бежевый фон с бликами
![Фон боке]()
Фон боке
![Блики боке]()
Блики боке
![Боке для фотошопа]()
Боке для фотошопа
![Блестки на белом фоне]()
Блестки на белом фоне
![Светлый фон]()
Светлый фон
![Прозрачные блики]()
Прозрачные блики
![Эффект боке]()
Эффект боке
![Желтые блики на прозрачном фоне]()
Желтые блики на прозрачном фоне
![Белый блик]()
Белый блик
![Боке для фотошопа]()
Боке для фотошопа
![Белый блик]()
Белый блик
![Блики боке]()
Блики боке
![Блики на прозрачном фоне]()
Блики на прозрачном фоне
![Бежевое боке]()
Бежевое боке
![Фон боке]()
Фон боке
![Белый блик]()
Белый блик
![Боке для фотошопа на прозрачном фоне]()
Боке для фотошопа на прозрачном фоне
![Эффект боке]()
Эффект боке
![Белые блестки]()
Белые блестки
![Прозрачные блики]()
Прозрачные блики
![Оранжевые блики на прозрачном фоне]()
Оранжевые блики на прозрачном фоне
![Полупрозрачный белый фон]()
Полупрозрачный белый фон
![Боке для фотошопа]()
Боке для фотошопа
![Новогодние огоньки]()
Новогодние огоньки
![Фон блики]()
Фон блики
![Фон боке светлый]()
Фон боке светлый
![Серые блики]()
Серые блики
![Блики текстура]()
Блики текстура
![Белый фон с блестками]()
Белый фон с блестками
![Золотые блики]()
Золотые блики
![Белый блик]()
Белый блик
Смотрите онлайн или можете скачать на телефон или компьютер в хорошем качестве совешенно бесплатно. Не забывайте оставить комментарий и посмотреть другие фотографии и изображения высокого качества, например белый автомобиль на прозрачном фоне и искра белая на прозрачном фоне из раздела Белые

Grizly.club
Grizly.club